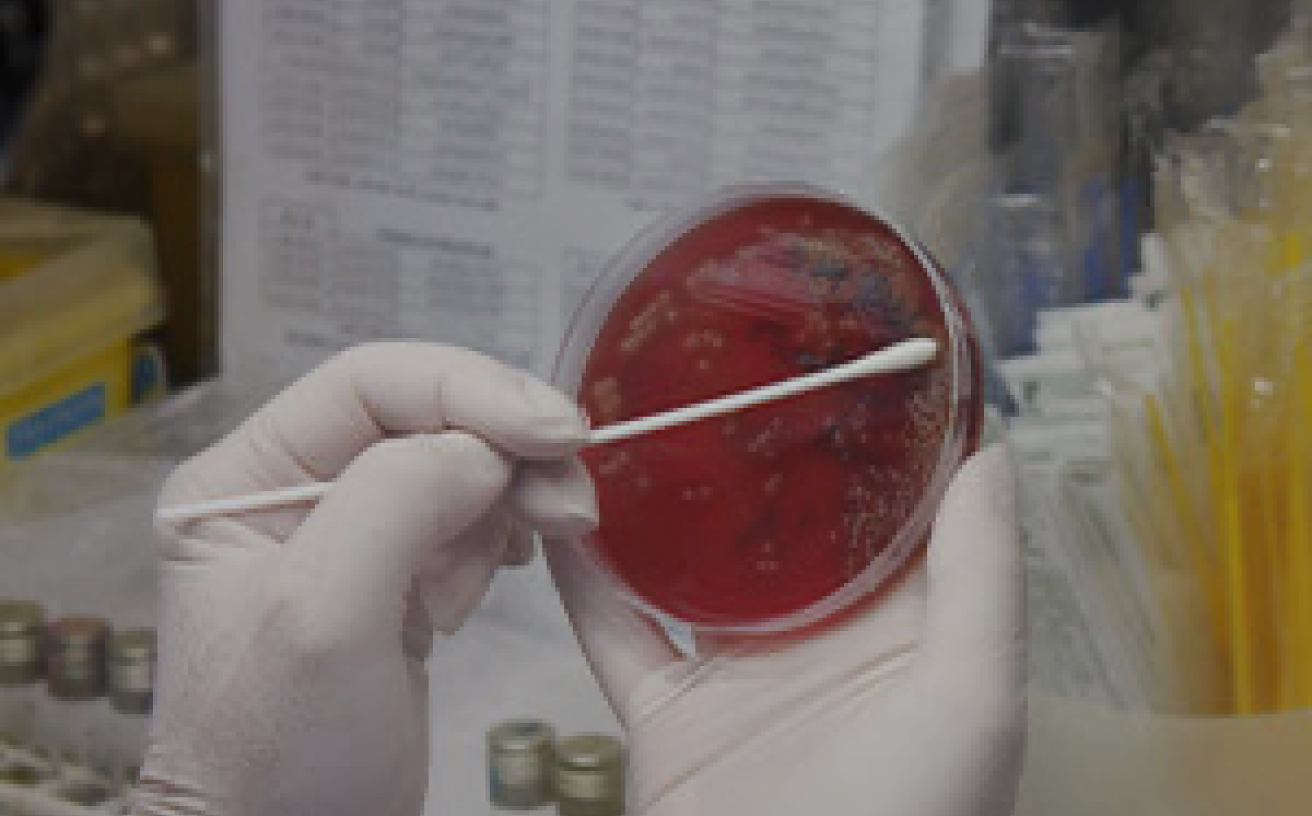

Resultados de exames

Setores e exames

Hematologia
Estudo da fisiologia e patologia envolvendo o sangue, medula óssea e linfonodos.
Exames
Bacteriologia e Micologia
Identifica doenças fúngicas e bacterianas que podem causar infecções, dermatites e outros.
Exames

Biologia Molecular (PCR)
Diagnóstico de doenças infecciosas e parasitológicas com alto grau de especifidade, evitando falsos resultados.
Exames

Hormônios
Exames

Bioquímica
Exames

Histologia e Citologia
Exames

Parasitologia
Exames

Urinálise
Exames

Imunológicos
Exames